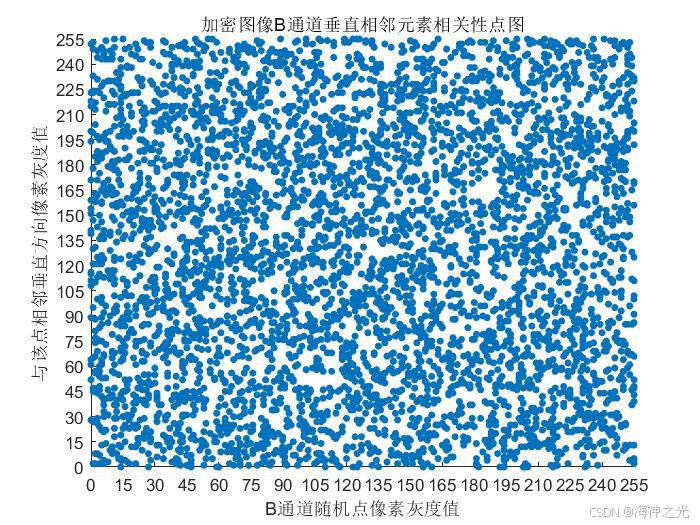
在这里插入图片描述
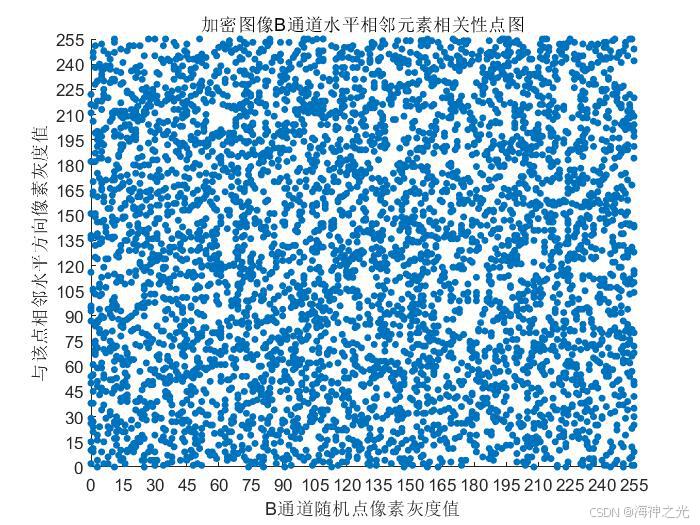
在这里插入图片描述
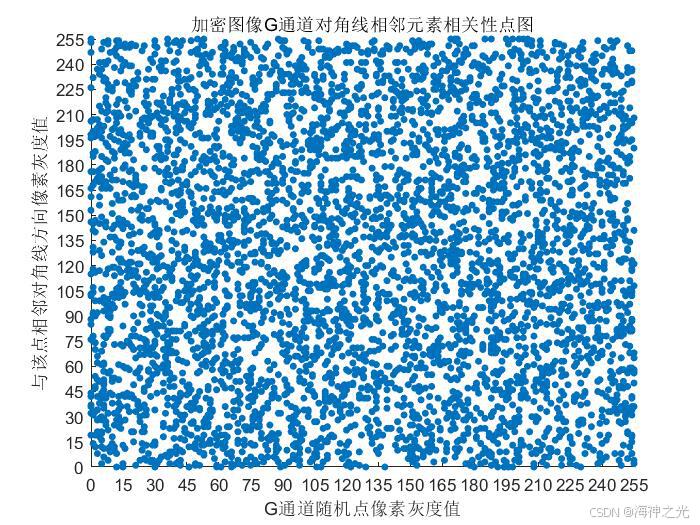
在这里插入图片描述
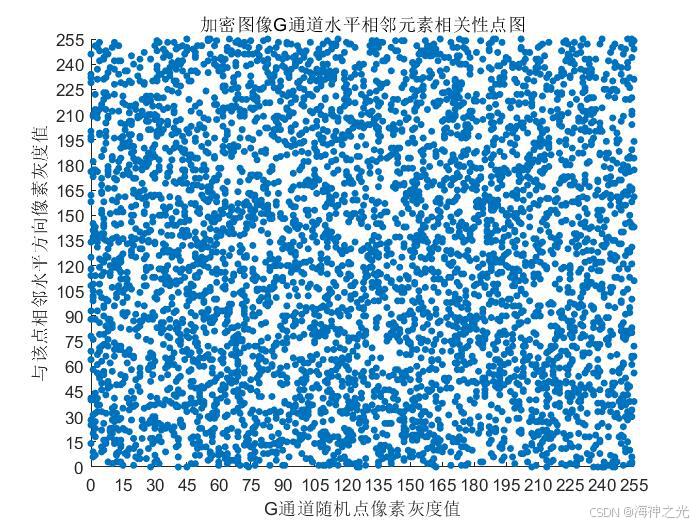
在这里插入图片描述
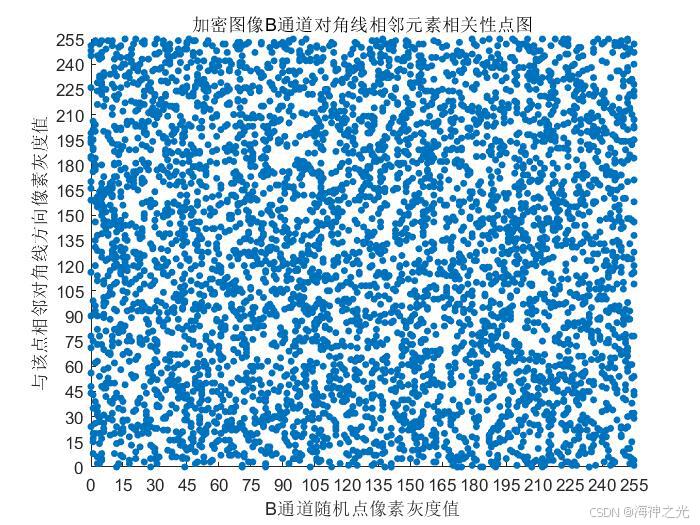
在这里插入图片描述
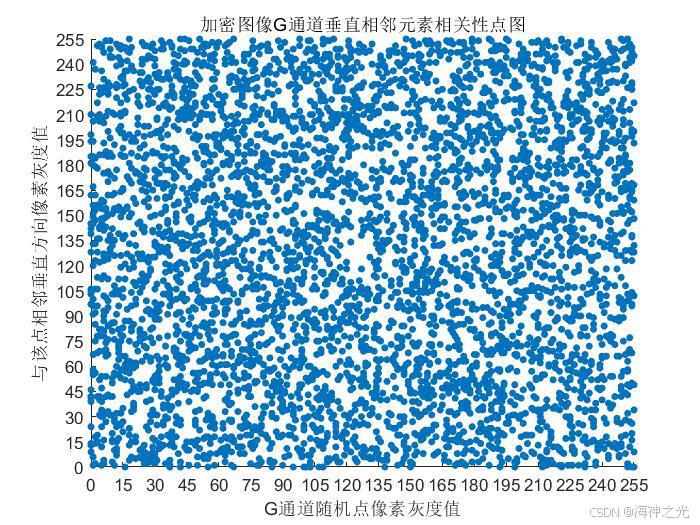
在这里插入图片描述
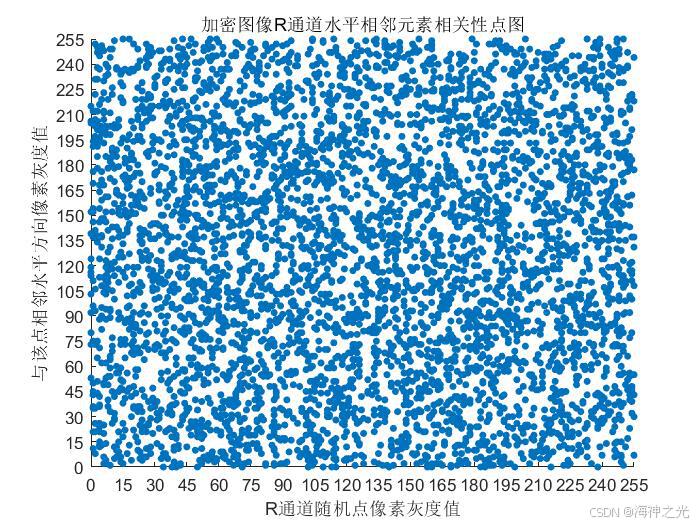
在这里插入图片描述

💥💥💥💥💥💥💥💥💞💞💞💞💞💞💞💞💞Matlab武动乾坤博客之家💞💞💞💞💞💞💞💞💞💥💥💥💥💥💥💥💥
🚀🚀🚀🚀🚀🚀🚀🚀🚀🚀🚤🚤🚤🚤🚤🚤🚤🚤🚤🚤🚤🚤🚤🚤🚤🚤🚤🚤🚤🚤🚀🚀🚀🚀🚀🚀🚀🚀🚀🚀

🔊博主简介:985研究生,Matlab领域科研开发者;
🚅座右铭:行百里者,半于九十。
🏆代码获取方式:
优快云 Matlab武动乾坤—代码获取方式
更多Matlab图像处理仿真内容点击👇
①Matlab图像处理(进阶版)
⛳️关注优快云 Matlab武动乾坤,更多资源等你来!!
⛄一、混沌系统和DNA编码图像加密解密
1 混沌系统在图像加密中的应用
混沌系统因其对初始条件的极端敏感性和伪随机性,常被用于图像加密领域。典型的混沌系统包括Logistic映射、Lorenz系统、Chen系统等。这些系统能生成复杂的伪随机序列,为图像像素置换和扩散提供密钥流。
Logistic映射的数学表达式为:
x
n
+
1
=
μ
x
n
(
1
−
x
n
)
x_{n+1} = \mu x_n (1 - x_n)
xn+1=μxn(1−xn)
其中
μ
∈
[
3.57
,
4
]
\mu \in [3.57,4]
μ∈[3.57,4]时系统进入混沌状态,微小初始值差异会导致完全不同的序列。
2 DNA编码基本原理
DNA编码利用生物DNA的四种碱基(A-腺嘌呤、T-胸腺嘧啶、C-胞嘧啶、G-鸟嘌呤)进行数据表示。在图像加密中,每个像素值(0-255)可转换为8位二进制,再映射为4个DNA碱基。常见编码规则如下:
- 00→A, 01→T, 10→C, 11→G
- 00→G, 01→C, 10→T, 11→A
3 基于混沌与DNA的加密流程
密钥生成阶段
利用混沌系统初始值生成密钥流。例如采用Logistic映射生成两组序列
K
1
K_1
K1和
K
2
K_2
K2,通过量化处理得到用于像素置换和DNA运算的密钥矩阵。
像素级加密操作
- 将原始图像矩阵转换为二进制形式,按照选定规则编码为DNA序列矩阵
- 使用混沌序列对DNA矩阵进行位置置换(如Arnold变换)
- 执行DNA碱基运算(互补、异或等),例如:
A ⊕ T = C , C ⊕ G = A A \oplus T = C, \quad C \oplus G = A A⊕T=C,C⊕G=A
扩散增强安全性
通过混沌序列控制像素值扩散过程,修改每个像素值使其与相邻像素及密钥关联:
P
i
′
=
(
P
i
+
K
i
+
P
i
−
1
′
)
m
o
d
256
P'_i = (P_i + K_i + P'_{i-1}) \mod 256
Pi′=(Pi+Ki+Pi−1′)mod256
4 解密流程设计
解密为加密的逆过程:
- 用相同初始值重现混沌序列
- 逆向执行DNA碱基运算
- 反置换操作恢复原始位置
- DNA解码转换回像素矩阵
关键点在于严格保持加密时的参数一致性,包括混沌初始值、DNA编码规则和运算顺序。
5 典型改进方案示例
多混沌系统组合
采用超混沌系统(如4D超混沌)增强密钥空间:
{
x
˙
=
a
(
y
−
x
)
+
y
w
y
˙
=
c
x
−
x
z
−
y
z
˙
=
x
y
−
b
z
w
˙
=
−
x
z
+
d
w
\begin{cases} \dot{x} = a(y-x)+yw \\ \dot{y} = cx-xz-y \\ \dot{z} = xy-bz \\ \dot{w} = -xz+dw \end{cases}
⎩
⎨
⎧x˙=a(y−x)+ywy˙=cx−xz−yz˙=xy−bzw˙=−xz+dw
动态DNA编码
根据混沌序列实时切换编码规则表,提升抗攻击能力。例如每处理8个像素后,按混沌序列值选择6种预设编码规则之一。
6 安全性评估指标
- 密钥敏感性测试:初始密钥 10 − 15 10^{-15} 10−15量级变化应导致解密完全失败
- 直方图分析:加密图像像素值应呈均匀分布
- 相关性系数:相邻像素相关系数应接近0(原始图像约0.9)
- 信息熵:加密图像信息熵应接近理论最大值8(对于8位灰度图)
- 差分攻击抵抗:NPCR(像素变化率)>99.6%,UACI(统一平均变化强度)>33.4%
7 实现示例(Python关键代码)
import numpy as np
from PIL import Image
# Logistic混沌序列生成
def logistic_map(x0, mu, length):
sequence = []
for _ in range(length):
x0 = mu * x0 * (1 - x0)
sequence.append(x0)
return np.array(sequence)
# DNA编码函数
def dna_encode(pixel, rule=1):
binary = f"{pixel:08b}"
dna_map = {
0: ['00','01','10','11'],
1: ['A','T','C','G'],
2: ['G','C','T','A']
}[rule]
return ''.join([dna_map[int(binary[i:i+2],2)] for i in range(0,8,2)])
# 示例加密流程
def encrypt_image(img_path, x0=0.123, mu=3.99):
img = np.array(Image.open(img_path))
h, w = img.shape
# 生成混沌序列
chaos_seq = logistic_map(x0, mu, h*w*4)
# 后续实现DNA编码和置换操作...
⛄二、部分源代码和运行步骤
2.1 部分代码
2.2 通用运行步骤
(1)直接运行main.m即可一键出图
⛄三、运行结果

⛄四、matlab版本及参考文献
1 matlab版本
2019b
2 参考文献
[1]赖庆明.基于Arnold变换的图像加密算法验证[J].电子质量. 2015
3 备注
简介此部分摘自互联网,仅供参考,若侵权,联系删除
🍅 仿真咨询
1 各类智能优化算法改进及应用
1.1 PID优化
1.2 VMD优化
1.3 配电网重构
1.4 三维装箱
1.5 微电网优化
1.6 优化布局
1.7 优化参数
1.8 优化成本
1.9 优化充电
1.10 优化调度
1.11 优化电价
1.12 优化发车
1.13 优化分配
1.14 优化覆盖
1.15 优化控制
1.16 优化库存
1.17 优化路由
1.18 优化设计
1.19 优化位置
1.20 优化吸波
1.21 优化选址
1.22 优化运行
1.23 优化指派
1.24 优化组合
1.25 车间调度
1.26 生产调度
1.27 经济调度
1.28 装配线调度
1.29 水库调度
1.30 货位优化
1.31 公交排班优化
1.32 集装箱船配载优化
1.33 水泵组合优化
1.34 医疗资源分配优化
1.35 可视域基站和无人机选址优化
2 机器学习和深度学习分类与预测
2.1 机器学习和深度学习分类
2.1.1 BiLSTM双向长短时记忆神经网络分类
2.1.2 BP神经网络分类
2.1.3 CNN卷积神经网络分类
2.1.4 DBN深度置信网络分类
2.1.5 DELM深度学习极限学习机分类
2.1.6 ELMAN递归神经网络分类
2.1.7 ELM极限学习机分类
2.1.8 GRNN广义回归神经网络分类
2.1.9 GRU门控循环单元分类
2.1.10 KELM混合核极限学习机分类
2.1.11 KNN分类
2.1.12 LSSVM最小二乘法支持向量机分类
2.1.13 LSTM长短时记忆网络分类
2.1.14 MLP全连接神经网络分类
2.1.15 PNN概率神经网络分类
2.1.16 RELM鲁棒极限学习机分类
2.1.17 RF随机森林分类
2.1.18 SCN随机配置网络模型分类
2.1.19 SVM支持向量机分类
2.1.20 XGBOOST分类
2.2 机器学习和深度学习预测
2.2.1 ANFIS自适应模糊神经网络预测
2.2.2 ANN人工神经网络预测
2.2.3 ARMA自回归滑动平均模型预测
2.2.4 BF粒子滤波预测
2.2.5 BiLSTM双向长短时记忆神经网络预测
2.2.6 BLS宽度学习神经网络预测
2.2.7 BP神经网络预测
2.2.8 CNN卷积神经网络预测
2.2.9 DBN深度置信网络预测
2.2.10 DELM深度学习极限学习机预测
2.2.11 DKELM回归预测
2.2.12 ELMAN递归神经网络预测
2.2.13 ELM极限学习机预测
2.2.14 ESN回声状态网络预测
2.2.15 FNN前馈神经网络预测
2.2.16 GMDN预测
2.2.17 GMM高斯混合模型预测
2.2.18 GRNN广义回归神经网络预测
2.2.19 GRU门控循环单元预测
2.2.20 KELM混合核极限学习机预测
2.2.21 LMS最小均方算法预测
2.2.22 LSSVM最小二乘法支持向量机预测
2.2.23 LSTM长短时记忆网络预测
2.2.24 RBF径向基函数神经网络预测
2.2.25 RELM鲁棒极限学习机预测
2.2.26 RF随机森林预测
2.2.27 RNN循环神经网络预测
2.2.28 RVM相关向量机预测
2.2.29 SVM支持向量机预测
2.2.30 TCN时间卷积神经网络预测
2.2.31 XGBoost回归预测
2.2.32 模糊预测
2.2.33 奇异谱分析方法SSA时间序列预测
2.3 机器学习和深度学习实际应用预测
CPI指数预测、PM2.5浓度预测、SOC预测、财务预警预测、产量预测、车位预测、虫情预测、带钢厚度预测、电池健康状态预测、电力负荷预测、房价预测、腐蚀率预测、故障诊断预测、光伏功率预测、轨迹预测、航空发动机寿命预测、汇率预测、混凝土强度预测、加热炉炉温预测、价格预测、交通流预测、居民消费指数预测、空气质量预测、粮食温度预测、气温预测、清水值预测、失业率预测、用电量预测、运输量预测、制造业采购经理指数预测
3 图像处理方面
3.1 图像边缘检测
3.2 图像处理
3.3 图像分割
3.4 图像分类
3.5 图像跟踪
3.6 图像加密解密
3.7 图像检索
3.8 图像配准
3.9 图像拼接
3.10 图像评价
3.11 图像去噪
3.12 图像融合
3.13 图像识别
3.13.1 表盘识别
3.13.2 车道线识别
3.13.3 车辆计数
3.13.4 车辆识别
3.13.5 车牌识别
3.13.6 车位识别
3.13.7 尺寸检测
3.13.8 答题卡识别
3.13.9 电器识别
3.13.10 跌倒检测
3.13.11 动物识别
3.13.12 二维码识别
3.13.13 发票识别
3.13.14 服装识别
3.13.15 汉字识别
3.13.16 红绿灯识别
3.13.17 虹膜识别
3.13.18 火灾检测
3.13.19 疾病分类
3.13.20 交通标志识别
3.13.21 卡号识别
3.13.22 口罩识别
3.13.23 裂缝识别
3.13.24 目标跟踪
3.13.25 疲劳检测
3.13.26 旗帜识别
3.13.27 青草识别
3.13.28 人脸识别
3.13.29 人民币识别
3.13.30 身份证识别
3.13.31 手势识别
3.13.32 数字字母识别
3.13.33 手掌识别
3.13.34 树叶识别
3.13.35 水果识别
3.13.36 条形码识别
3.13.37 温度检测
3.13.38 瑕疵检测
3.13.39 芯片检测
3.13.40 行为识别
3.13.41 验证码识别
3.13.42 药材识别
3.13.43 硬币识别
3.13.44 邮政编码识别
3.13.45 纸牌识别
3.13.46 指纹识别
3.14 图像修复
3.15 图像压缩
3.16 图像隐写
3.17 图像增强
3.18 图像重建
4 路径规划方面
4.1 旅行商问题(TSP)
4.1.1 单旅行商问题(TSP)
4.1.2 多旅行商问题(MTSP)
4.2 车辆路径问题(VRP)
4.2.1 车辆路径问题(VRP)
4.2.2 带容量的车辆路径问题(CVRP)
4.2.3 带容量+时间窗+距离车辆路径问题(DCTWVRP)
4.2.4 带容量+距离车辆路径问题(DCVRP)
4.2.5 带距离的车辆路径问题(DVRP)
4.2.6 带充电站+时间窗车辆路径问题(ETWVRP)
4.2.3 带多种容量的车辆路径问题(MCVRP)
4.2.4 带距离的多车辆路径问题(MDVRP)
4.2.5 同时取送货的车辆路径问题(SDVRP)
4.2.6 带时间窗+容量的车辆路径问题(TWCVRP)
4.2.6 带时间窗的车辆路径问题(TWVRP)
4.3 多式联运运输问题
4.4 机器人路径规划
4.4.1 避障路径规划
4.4.2 迷宫路径规划
4.4.3 栅格地图路径规划
4.5 配送路径规划
4.5.1 冷链配送路径规划
4.5.2 外卖配送路径规划
4.5.3 口罩配送路径规划
4.5.4 药品配送路径规划
4.5.5 含充电站配送路径规划
4.5.6 连锁超市配送路径规划
4.5.7 车辆协同无人机配送路径规划
4.6 无人机路径规划
4.6.1 飞行器仿真
4.6.2 无人机飞行作业
4.6.3 无人机轨迹跟踪
4.6.4 无人机集群仿真
4.6.5 无人机三维路径规划
4.6.6 无人机编队
4.6.7 无人机协同任务
4.6.8 无人机任务分配
5 语音处理
5.1 语音情感识别
5.2 声源定位
5.3 特征提取
5.4 语音编码
5.5 语音处理
5.6 语音分离
5.7 语音分析
5.8 语音合成
5.9 语音加密
5.10 语音去噪
5.11 语音识别
5.12 语音压缩
5.13 语音隐藏
6 元胞自动机方面
6.1 元胞自动机病毒仿真
6.2 元胞自动机城市规划
6.3 元胞自动机交通流
6.4 元胞自动机气体
6.5 元胞自动机人员疏散
6.6 元胞自动机森林火灾
6.7 元胞自动机生命游戏
7 信号处理方面
7.1 故障信号诊断分析
7.1.1 齿轮损伤识别
7.1.2 异步电机转子断条故障诊断
7.1.3 滚动体内外圈故障诊断分析
7.1.4 电机故障诊断分析
7.1.5 轴承故障诊断分析
7.1.6 齿轮箱故障诊断分析
7.1.7 三相逆变器故障诊断分析
7.1.8 柴油机故障诊断
7.2 雷达通信
7.2.1 FMCW仿真
7.2.2 GPS抗干扰
7.2.3 雷达LFM
7.2.4 雷达MIMO
7.2.5 雷达测角
7.2.6 雷达成像
7.2.7 雷达定位
7.2.8 雷达回波
7.2.9 雷达检测
7.2.10 雷达数字信号处理
7.2.11 雷达通信
7.2.12 雷达相控阵
7.2.13 雷达信号分析
7.2.14 雷达预警
7.2.15 雷达脉冲压缩
7.2.16 天线方向图
7.2.17 雷达杂波仿真
7.3 生物电信号
7.3.1 肌电信号EMG
7.3.2 脑电信号EEG
7.3.3 心电信号ECG
7.3.4 心脏仿真
7.4 通信系统
7.4.1 DOA估计
7.4.2 LEACH协议
7.4.3 编码译码
7.4.4 变分模态分解
7.4.5 超宽带仿真
7.4.6 多径衰落仿真
7.4.7 蜂窝网络
7.4.8 管道泄漏
7.4.9 经验模态分解
7.4.10 滤波器设计
7.4.11 模拟信号传输
7.4.12 模拟信号调制
7.4.13 数字基带信号
7.4.14 数字信道
7.4.15 数字信号处理
7.4.16 数字信号传输
7.4.17 数字信号去噪
7.4.18 水声通信
7.4.19 通信仿真
7.4.20 无线传输
7.4.21 误码率仿真
7.4.22 现代通信
7.4.23 信道估计
7.4.24 信号检测
7.4.25 信号融合
7.4.26 信号识别
7.4.27 压缩感知
7.4.28 噪声仿真
7.4.29 噪声干扰
7.5 无人机通信
7.6 无线传感器定位及布局方面
7.6.1 WSN定位
7.6.2 高度预估
7.6.3 滤波跟踪
7.6.4 目标定位
7.6.4.1 Dv-Hop定位
7.6.4.2 RSSI定位
7.6.4.3 智能算法优化定位
7.6.5 组合导航
8 电力系统方面
微电网优化、无功优化、配电网重构、储能配置
655

被折叠的 条评论
为什么被折叠?



